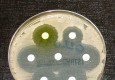
thumbnail preview

Vijesti označene tagom: karbapenemi

Od posljedica zaraze superbakterijama otpornim na brojne poznate antibiotike svake godine umre oko 33.000 Europljana, podaci su Europskoga centra za prevenciju i kontrolu bolesti (ECDC), u čijem izvješću stoji da su posljedice tih bolesti usporedive s posljedicama smrtnih…